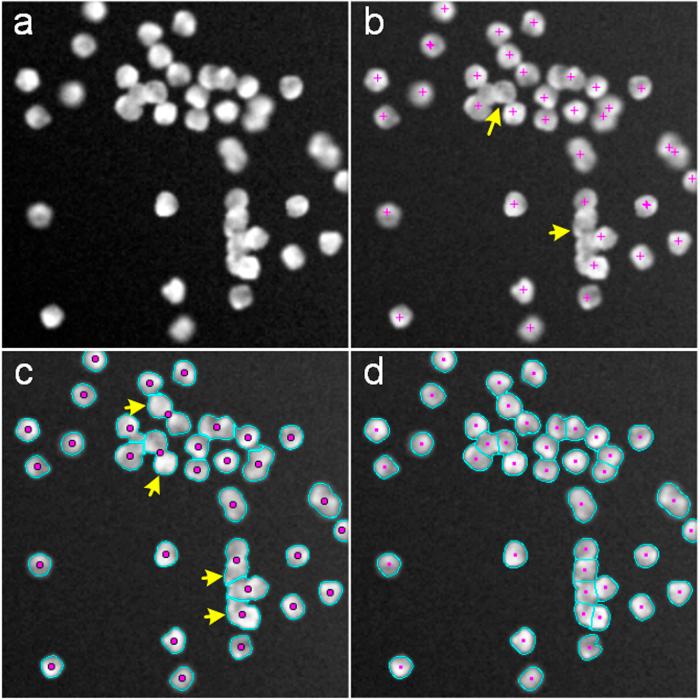
https://cdn.ncbi.nlm.nih.gov/pmc/blobs/c8d1/4501004/1052b109efca/srep12089-f3.jpg

iCut:一种集成切割算法可实现对接触细胞的精确分割。
iCut: an Integrative Cut Algorithm Enables Accurate Segmentation of Touching Cells.
作者信息
He Yong, Gong Hui, Xiong Benyi, Xu Xiaofeng, Li Anan, Jiang Tao, Sun Qingtao, Wang Simin, Luo Qingming, Chen Shangbin
机构信息
1] Britton Chance Center for Biomedical Photonics, Huazhong University of Science and Technology-Wuhan National Laboratory for Optoelectronics, Wuhan, Hubei, China [2] MoE Key Laboratory for Biomedical Photonics, Department of Biomedical Engineering, Huazhong University of Science and Technology, Wuhan, Hubei, China.
出版信息
Sci Rep. 2015 Jul 14;5:12089. doi: 10.1038/srep12089.
Individual cells play essential roles in the biological processes of the brain. The number of neurons changes during both normal development and disease progression. High-resolution imaging has made it possible to directly count cells. However, the automatic and precise segmentation of touching cells continues to be a major challenge for massive and highly complex datasets. Thus, an integrative cut (iCut) algorithm, which combines information regarding spatial location and intervening and concave contours with the established normalized cut, has been developed. iCut involves two key steps: (1) a weighting matrix is first constructed with the abovementioned information regarding the touching cells and (2) a normalized cut algorithm that uses the weighting matrix is implemented to separate the touching cells into isolated cells. This novel algorithm was evaluated using two types of data: the open SIMCEP benchmark dataset and our micro-optical imaging dataset from a Nissl-stained mouse brain. It has achieved a promising recall/precision of 91.2 ± 2.1%/94.1 ± 1.8% and 86.8 ± 4.1%/87.5 ± 5.7%, respectively, for the two datasets. As quantified using the harmonic mean of recall and precision, the accuracy of iCut is higher than that of some state-of-the-art algorithms. The better performance of this fully automated algorithm can benefit studies of brain cytoarchitecture.
单个细胞在大脑的生物过程中发挥着重要作用。在正常发育和疾病进展过程中,神经元的数量都会发生变化。高分辨率成像使得直接对细胞进行计数成为可能。然而,对于大规模且高度复杂的数据集而言,对相互接触的细胞进行自动且精确的分割仍然是一项重大挑战。因此,一种整合切割(iCut)算法应运而生,该算法将关于空间位置、居间和凹面轮廓的信息与已有的归一化切割相结合。iCut算法包含两个关键步骤:(1)首先利用上述关于相互接触细胞的信息构建一个权重矩阵;(2)实施一种使用该权重矩阵的归一化切割算法,将相互接触的细胞分离为单个细胞。我们使用两种类型的数据对这种新算法进行了评估:开放的SIMCEP基准数据集以及我们从经尼氏染色的小鼠大脑获取的微光学成像数据集。对于这两个数据集,该算法分别取得了91.2±2.1%/94.1±1.8%和86.8±4.1%/87.5±5.7%的召回率/精确率,表现令人满意。通过使用召回率和精确率的调和平均值进行量化,iCut算法的准确性高于一些最先进的算法。这种全自动算法的更好性能将有助于大脑细胞结构的研究。